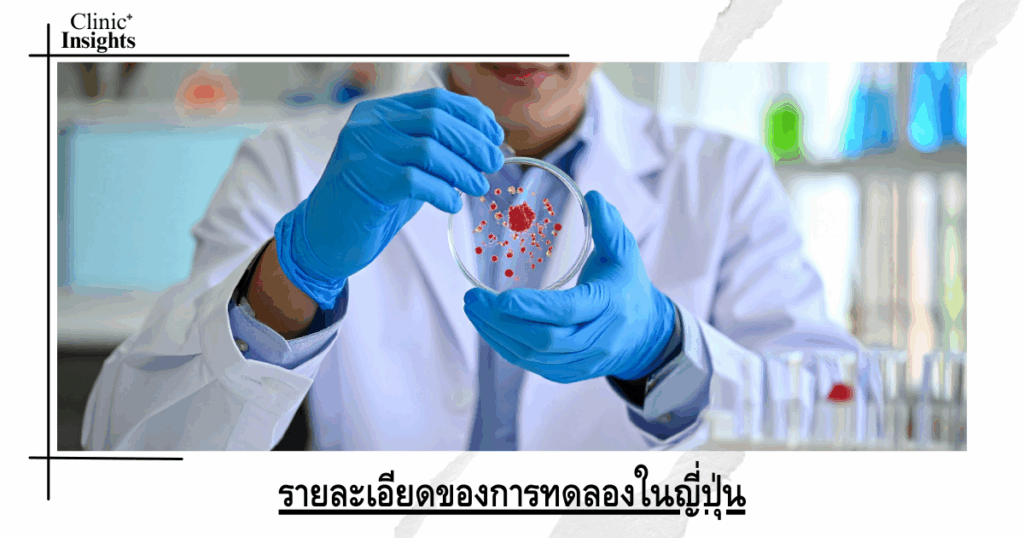
Details of the experiment in Japan

เจาะเลือดครั้งเดียวรู้เรื่อง! สิงคโปร์เปิดตัว “ชุดตรวจมะเร็งหลายชนิด” สุดล้ำ คัดกรองโรคร้ายได้สูงสุด 50 ประเภท พร้อมใช้เมษายน 2569
สิงคโปร์ประกาศความเป็นผู้นำด้านนวัตกรรมการแพทย์แม่นยำ ( […]
ญี่ปุ่นเป็นประเทศที่มีสัดส่วนผู้สูงอายุสูงที่สุด ทำให้การวิจัยด้านชะลอความเสื่อมได้รับความสนใจอย่างมาก ล่าสุดนักวิทยาศาสตร์ญี่ปุ่นเริ่มทดลองยากลุ่ม Senolytics ในมนุษย์เป็นครั้งแรก โดยตั้งเป้าศึกษาประสิทธิภาพด้านการลดเซลล์เสื่อมสภาพที่สะสมในร่างกาย เป็นปัจจัยสำคัญที่เชื่อมโยงกับโรคเสื่อมหลายชนิด การทดลองครั้งนี้ถือเป็นความคืบหน้าในวงการแพทย์ระดับนานาชาติ เพราะ Senolytics เคยถูกศึกษาในสัตว์ทดลองและแสดงผลลัพธ์ที่น่าสนใจ แต่ยังไม่เคยมีการทดสอบในมนุษย์อย่างเป็นระบบมาก่อน

สารบัญเนื้อหา
Toggleเซลล์เสื่อมสภาพหรือ Senescent cells เป็นเซลล์ที่หยุดแบ่งตัว แต่ยังคงอยู่ในร่างกายและปล่อยสารที่ส่งผลต่อเนื้อเยื่อโดยรอบ หากสะสมมากจะเกี่ยวข้องกับปัญหาสุขภาพหลายชนิด เช่น
ยากลุ่ม Senolytics ทำหน้าที่กำจัดเซลล์ที่หมดสภาพเหล่านี้ ช่วยลดการอักเสบในระดับเซลล์และอาจช่วยให้เนื้อเยื่อฟื้นฟูได้ดีขึ้น นักวิทยาศาสตร์มองว่านี่อาจเป็นแนวทางใหม่ของการแพทย์เชิงป้องกัน ที่เน้นการจัดการต้นเหตุของความเสื่อมมากกว่ารักษาตามอาการ
การทดลองถูกออกแบบในกลุ่มอาสาสมัครวัยกลางคนจนถึงผู้สูงอายุที่มีภาวะเกี่ยวกับการเสื่อมระดับเริ่มต้น โดยเน้นการประเมินความปลอดภัย ผลข้างเคียง และระดับการลดลงของเซลล์เสื่อมสภาพในร่างกาย
ขั้นตอนการทดลองประกอบด้วย
ช่วงทดลองแรกจะเน้นประเมินความปลอดภัยเป็นสำคัญ ก่อนขยับไปสู่การประเมินประสิทธิภาพในการชะลอความเสื่อมของเนื้อเยื่อ
ญี่ปุ่นมีประชากรอายุเกิน 65 ปีมากกว่า 30 เปอร์เซ็นต์ ทำให้ปัญหาโรคเสื่อมและโรคเรื้อรังเพิ่มขึ้นอย่างต่อเนื่อง การพัฒนายาที่ช่วยลดการเสื่อมระดับเซลล์จึงตอบโจทย์ทั้งด้านสาธารณสุขและคุณภาพชีวิตของผู้สูงอายุ รัฐบาลญี่ปุ่นยังสนับสนุนงานวิจัยด้านเวชศาสตร์ชะลอวัยอย่างเป็นระบบ ทั้งเพื่อพัฒนานวัตกรรมภายในประเทศ และเป็นฐานเศรษฐกิจใหม่

งานวิจัยในสัตว์ทดลองจะพบประโยชน์หลายด้าน แต่การใช้ในมนุษย์ยังเป็นเรื่องใหม่มาก นักวิจัยทั่วโลกติดตามความคืบหน้าของญี่ปุ่นอย่างใกล้ชิด เพราะหากผลลัพธ์ออกมาเป็นบวก อาจนำไปสู่การพัฒนายาในแนวทางใหม่ที่ช่วยลดความเสี่ยงโรคเรื้อรังในกลุ่มวัยกลางคนและผู้สูงอายุ
แพทย์เน้นว่าการศึกษาในมนุษย์ต้องใช้เวลา ตรวจสอบอย่างละเอียด และต้องไม่สร้างความคาดหวังเกินจริง เพราะการชะลอวัยเป็นกระบวนการซับซ้อนที่เกี่ยวข้องกับหลายระบบในร่างกาย
หากการทดลองเป็นไปด้วยดี วงการแพทย์อาจมีทางเลือกใหม่ที่ช่วยลดการเสื่อมของเนื้อเยื่อได้ตั้งแต่ระยะต้น สร้างแนวทางใหม่ในการดูแลผู้สูงอายุ และช่วยลดภาระในระบบสาธารณสุข แนวคิดนี้ไม่ได้มุ่งทำให้มนุษย์อายุยืนขึ้นอย่างเดียว แต่เน้นให้มีสุขภาพที่ดีขึ้นในช่วงอายุที่เพิ่มขึ้น นับเป็นอีกก้าวสำคัญของงานวิจัยด้านชะลอความเสื่อมที่ทั่วโลกจับตา
เขียน/เรียบเรียง โดย ClinicInsights.asia
สิงคโปร์ประกาศความเป็นผู้นำด้านนวัตกรรมการแพทย์แม่นยำ ( […]
จีนตอกย้ำความเป็นผู้นำด้านเทคโนโลยีทางการแพทย์ระดับโลก […]
ฝันที่เป็นจริงของคนฟันหลอ วงการทันตกรรมโลกต้องจารึกประว […]
เกาหลีใต้ประกาศความสำเร็จครั้งสำคัญในการรักษาสุขภาพจิต […]
ภาวะสมองเสื่อมหรืออัลไซเมอร์เป็นหนึ่งในความท้าทายที่ใหญ […]
โครงการรหัสพันธุกรรมแห่งชาติสิงคโปร์หรือ National Preci […]
วงการแพทย์ 2026 การดูแลสุขภาพไม่ได้จำกัดอยู่เพียงการรับ […]
นับเป็นก้าวกระโดดที่สำคัญของวงการวิจัยระดับโลกเมื่อคณะผ […]
องค์การอนามัยโลก (WHO) พร้อมด้วยภาคีเครือข่ายระดับนานาช […]